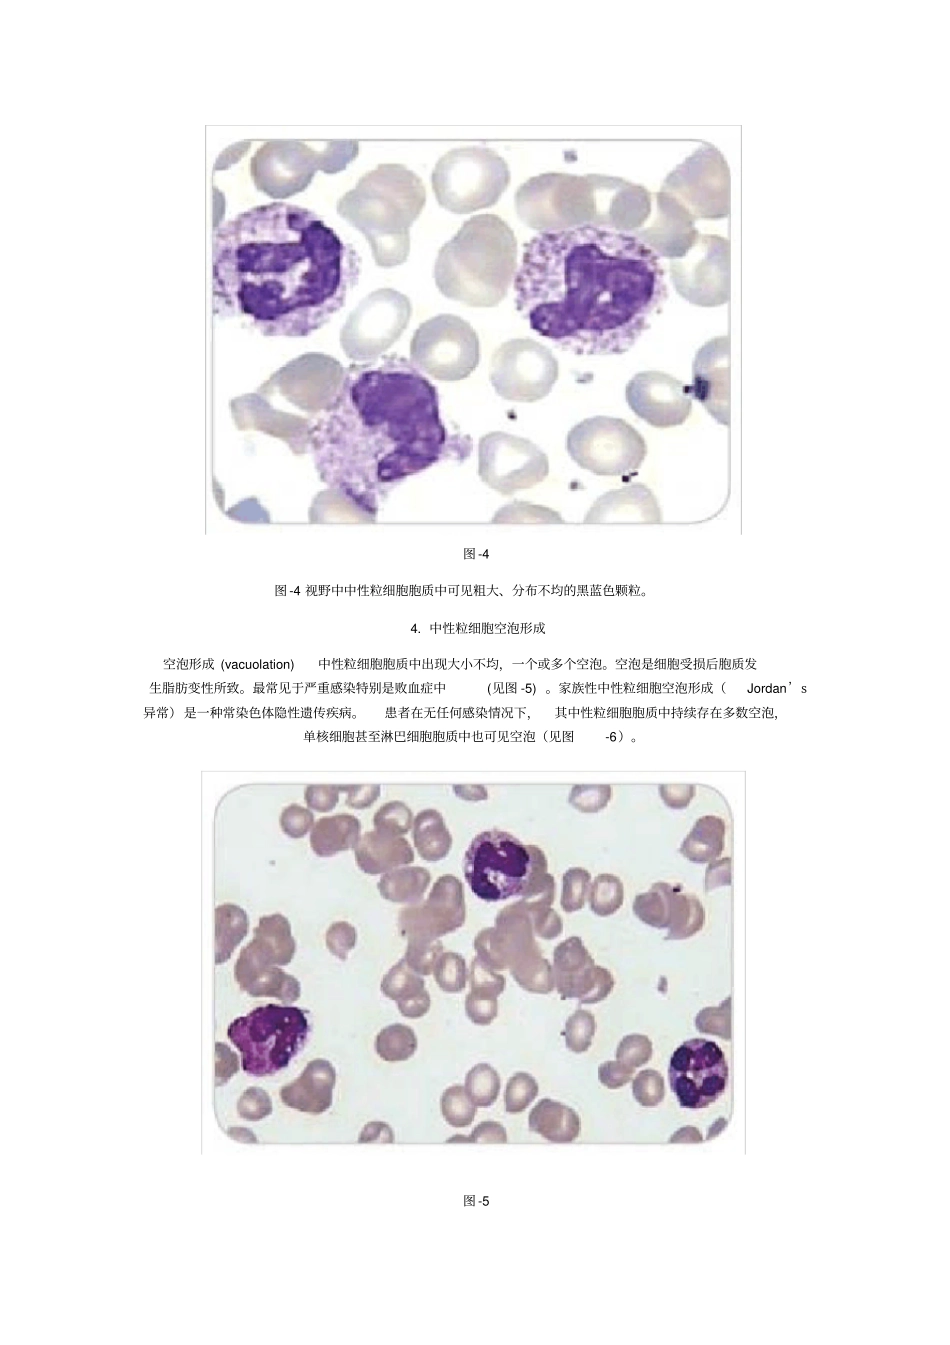
末梢血涂片白细胞形态变化及临床意义_第3页

末梢血涂片白细胞形态变化及临床意义1
中性粒细胞核左移2
外周血中性杆状粒细胞增高,并可见晚幼粒细胞、中幼粒细胞甚至早幼粒细胞时称为中性粒细胞核左移
仅见杆状粒细胞>6% 时,称为轻度核左移;杆状粒细胞>10% ,伴少量晚幼粒细胞、中幼粒细胞时称为中度核左移;杆状粒细胞>25% ,出现更幼稚的粒细胞如早幼粒细胞甚至原粒细胞时称为重度核左移
重度核左移又称为类白血病反应,此时中性粒细胞常伴有明显的中毒性病理改变
中性粒细胞核左移常见于急性化脓性感染、急性中毒、急性溶血等
骨髓增生异常综合征(MDS )患者外周血可见原始、幼稚粒细胞,并出现病态造血,如中性粒细胞核分叶不良等
图 -1 图 -2 图-1 视野可见中性分叶粒细胞、中性杆状粒细胞、中性晚幼和中幼粒细胞
中性粒细胞胞质中可见中毒颗粒
图 -2 可见中性分叶粒细胞、中性杆状粒细胞、中幼粒细胞和早幼粒细胞
中性粒细胞胞质中可见中毒颗粒
中性粒细胞核右移正常成熟中性粒细胞胞核以分三叶者为主,如血片中五叶核中性粒细胞>3% ,则称为中性粒细胞核右移
核右移常伴有白细胞总数减低和中性粒细胞胞体增大,常见于巨幼细胞性贫血及恶性贫血等
其原因主要是由于缺乏叶酸、 VitB12 等造血物质, DNA 合成减少,影响了细胞的正常分裂
在应用某些抗核酸代谢药物及炎症恢复期等也可见核右移现象
图 -3 图 -3 视野中可见一巨大中性粒细胞,胞核分为10 余叶
中性粒细胞中毒颗粒中毒颗粒 (toxic granulation) 中性粒细胞胞质中出现的粗大且分布不均的黑蓝色颗粒,称为中毒颗粒
中毒颗粒是细胞在生成特殊颗粒过程中受到某种阻力或发生颗粒变性所致
常见于严重的化脓菌感染及大面积烧伤等患者中
图 -4 图 -4 视野中中性粒细胞胞质中可见粗大、分布不均的黑蓝色颗粒
中性粒细胞空泡形成空泡形成 (vacuolatio